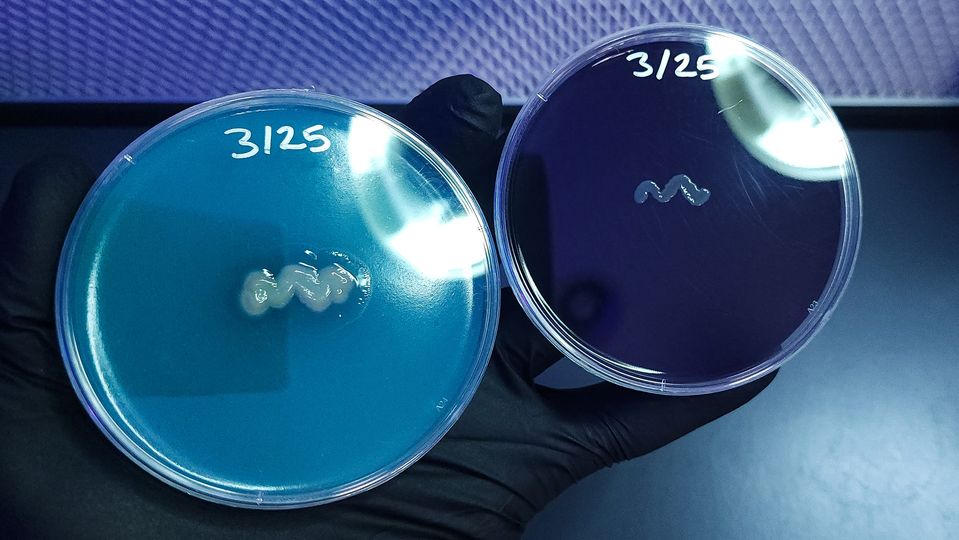
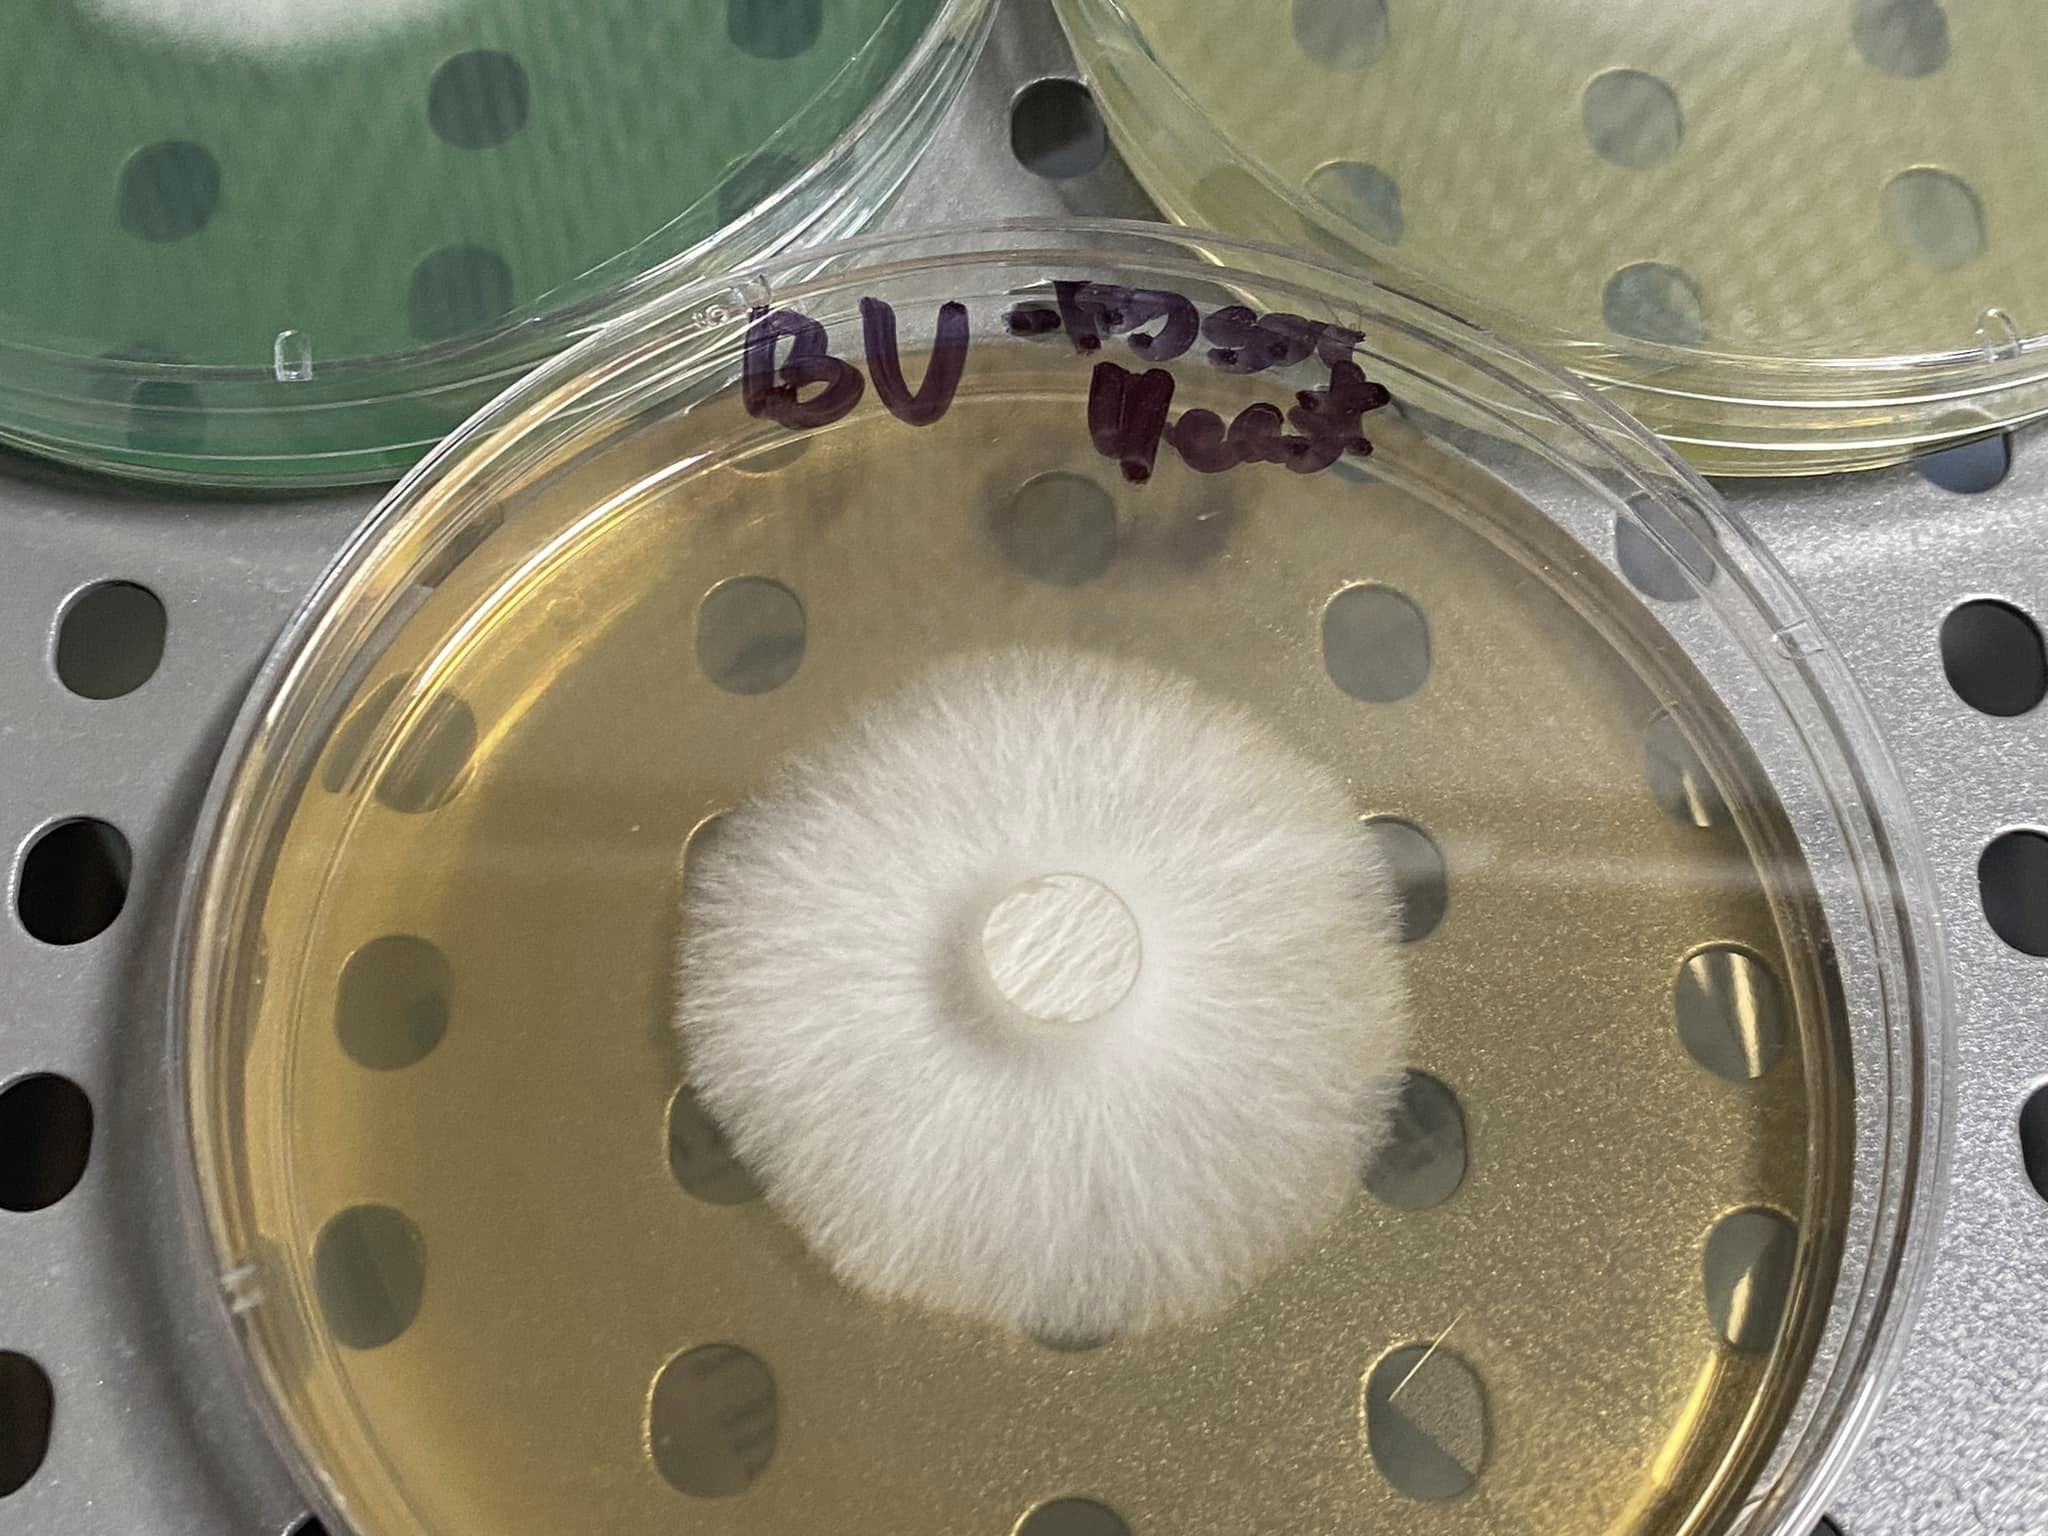

Medio de cultivo PDA

El PDA no es más que un gel nutritivo compuesto por papa dextrosa y agar (de ahí vienen sus siglas) que se encargara de dar alimento a nuestro micelio. Antes de comenzar un punto clave y condicional para tener éxito es la asepsia, es recomendable que desinfectemos cada superficie que vayamos a utilizar, de la misma manera cada instrumento que manipulemos en la zona de trabajo